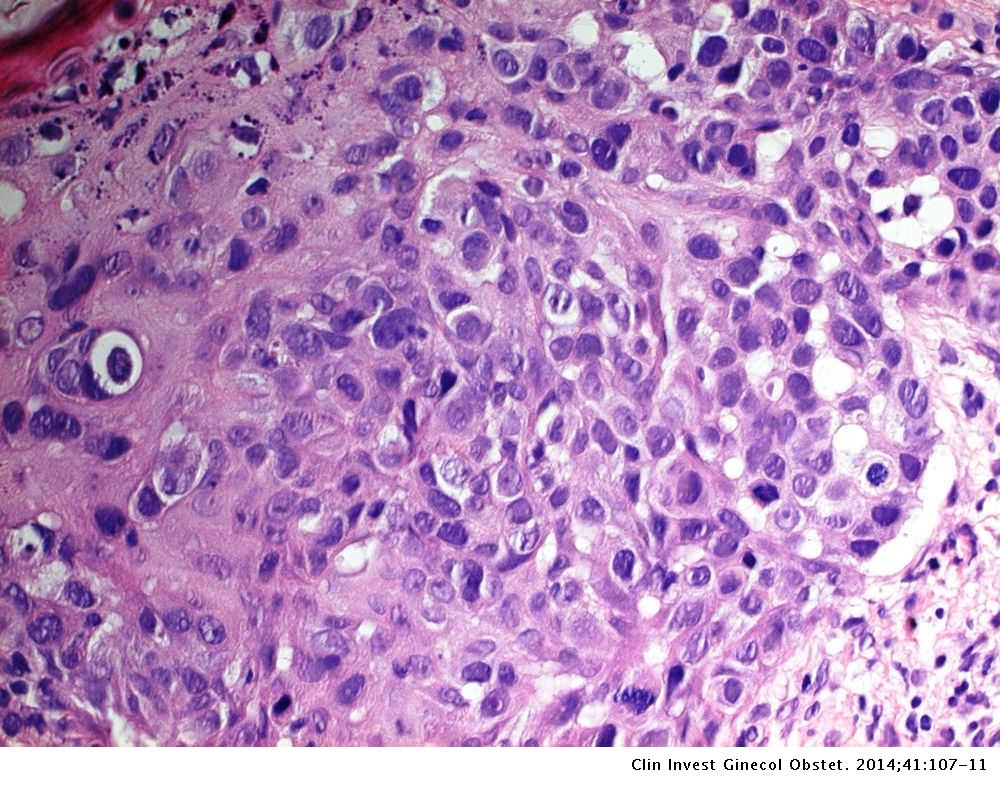

A doença de Paget é uma não invasivo tipo de câncer de mama que envolve o mamilo e a pele ao redor. É considerado não invasivo porque as células tumorais estão limitadas a uma camada da pele chamada epiderme. Acredita-se que a maioria dos tumores começa em canais chamados dutos que vão do mamilo até glândulas profundamente no peito. O crescimento de células anormais dentro dos.. A Doença de Paget é um tipo raro de câncer de mama que se manifesta como uma lesão inicialmente eczematosa (avermelhada, descamativa e que pode coçar), podendo…. Portal Câncer de Mama Brasil11 de novembro de 2018. Encontre um mastologista. Entre em contato com nossa equipe de mastologistas e agende uma consulta.

Sociedade Paranaense de Reumatologia Doença de Paget

(PDF) Doença de Paget da mama experiência de um centro universitário

Pigmented Mammary Paget Disease Dermoscopic, In Vivo ReflectanceMode Confocal Microscopic, and

Doença de Paget o que é e como tratar Clinica Croce

Doença de paget da papila Dr Pixel

Doença de Paget da Mama conheça este tipo raro de câncer mamário

🎗️ Telma doença de paget na mama YouTube

Symptoms And Causes Of Paget's Disease Of Bones

Entenda o que é a Doença de Paget Espaço Ortopedia

Image X Ray of the Skull in Paget Disease MSD诊疗手册专业版

Top 10 o que causa doença de paget na mama 2022
/GettyImages-960504232-591e86a151d2435f9433224606387c7d.jpg)
Paget’s Disease of the Breast Causes, Treatment, & More

Enfermedad de Paget de mama qué es, síntomas y prevención
Daniel.OrtoSport Doença de PAGET dos ossos em estágio avançado fotos.
La enfermedad de Paget de la mama en nuestra área revisión 19982012 Clínica e Investigación

A Doença de Paget no diagnóstico de Câncer de Mama. YouTube

Doença de Paget Osteíte deformante lista de medicamentos distribuídos nas Farmácias de Alto

Famosos com Doença De Paget Do Osso

Já ouviu falar sobre a doença de Paget dos mamilos? Fique atenta a esse raro câncer Itiruçu

ENFERMEDAD ÓSEA de PAGET Lenta, progresiva e invalidante
Doença de Paget. A Doença de Paget, descrita pela primeira vez em 1877, pelo médico inglês Sir James Paget, é um câncer raro que atinge o mamilo e a aréola e responde por entre 0,4% e 5% dos cânceres de mama. Ele é mais comum em mulheres na faixa dos 60 aos 70 anos e muito raramente atinge homens. Na Doença de Paget, a pele do mamilo.. Es fácil confundir los signos y síntomas de la enfermedad de Paget de la mama con irritación de la piel (dermatitis) u otra afección de la piel no cancerosa (benigna). Los posibles síntomas de la enfermedad de Paget de la mama incluyen: Piel escamosa o con escamas en el pezón. Piel dura o con costras o supuración que luce como un eccema.